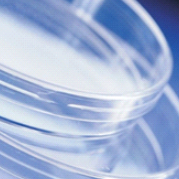
imagen

Cultive microorganismos en medios sólidos utilizando estas placas poco profund que maximizan el espacio de la incubadora y cuentan con un acabado de espejo que garantiza una alta calidad óptima.
Placas Petri
Diametros 30-140 mm 90 mm ·Fabricadas con poliestireno virgen no citotóxico. ·Idóneas para dispensadores automáticos de placas. ·Solo para uso in vitro y rutina en el laboratorio. ·Previene condensación.

Puntas
Tubos de microcentrífuga de alta calidad: 1.5 ml. Los tapones a presión de parte superior plana proporcionan un sello fiable y hermético incluso con ebullición prolongada. Polipropileno de alta claridad Graduaciones con rotulaciones de 0.1 y 0.25 ml. Resistencia a fuerzas de hasta 30,000 × g. Tapones de fácil apertura con punto de inserción para aguja y área de rotulación texturizada. Área de etiquetado en tubo exterior. Interior muy pulido para garantizar la máxima recuperación de la muestra Intervalo de temperaturas de - 80 °C a + 121 °C. Adaptación a todos los rotores estándar Apirógenos. Esterilización en autoclave a 121 °C/15 psi durante 15 minutos. Tubos cónicos preesterilizados para centrífuga Axygen™. Área de escritura para la identificación de muestras. Los tapones se cierran con una sola mano.

Swabs, aplicadores y Medios de Transporte para muestras
Productos de alta calidad y un solo uso para cada una de las necesidades de nuestros clientes tanto para la recolección como para transporte, mantenimiento y congelación a largo plazo. Ofrecemos productos tales como hisopos, aplicadores o depresores de lengua, productos de poliéster, algodón sin pelusa, madera y espuma resistente a químicos. Encontrará un producto que hará el trabajo en el cuidado de la salud, entornos críticos, aplicaciones forenses, de diagnóstico e industria. Convenientemente empaquetado y ofrecido tanto estéril como no estéril, encontrará la mejor calidad con nuestra líneas.

Cassete para Procesamiento de tejidos y Biopsias
1. Cassette para tejido en polímero de alta densidad. 2. Con aberturas de 1 mm que aseguran el máximo intercambio de fluidos. 3. Resistente a los solventes histológicos apto para sostener e identificar la muestra durante el procesamiento, embebido y seccionamiento. 4. Se adapta de forma segura al adaptador del micrótomo. 5. Disponible en 7 colores no citotóxicos.

Filtros Hepa
Los filtros de partículas de aire de alta eficiencia (HEPA) son los filtros de aire más eficientes disponibles en el mercado. Tienen una amplia aplicación en salas limpias y otras áreas que requieren los niveles más altos de control de contaminación. Protección de alto rendimiento para entornos críticos. Ofrece ahorros en los costos operativos generales al utilizar los medios HEPA / ULPA de flujo laminar de fibra de vidrio de menor resistencia en el mercado.